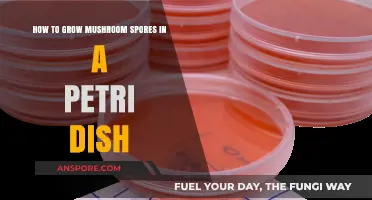
Cultivating Mushroom Spores: A Step-by-Step Petri Dish Guide

Growing mushroom spawn from spores is a fascinating and rewarding process that allows cultivators to propagate a wide variety of mushroom species. It begins with collecting or purchasing viable spores, which are typically suspended in a sterile solution or stored on spore prints. These spores are then introduced into a sterile substrate, such as agar or grain, where they germinate and develop into mycelium, the vegetative part of the fungus. Maintaining sterile conditions is crucial to prevent contamination by competing microorganisms. Once the mycelium has colonized the substrate, it can be transferred to a larger growing medium, such as sawdust or straw, to produce fruiting bodies. This method offers greater control over the genetic diversity and health of the mushrooms, making it a preferred technique for both hobbyists and commercial growers.
| Characteristics | Values |
|---|---|
| Spores Source | Collected from mature mushroom caps or purchased as spore syringes/prints. |
| Substrate Preparation | Sterilized grain (e.g., rye, wheat) or supplemented sawdust. |
| Sterilization Method | Pressure cooking at 15 psi for 60-90 minutes. |
| Spawn Container | Mason jars, grow bags, or sterile containers with filters. |
| Inoculation Environment | Sterile workspace (glove box or still air box). |
| Incubation Temperature | 70-75°F (21-24°C) for most mushroom species. |
| Incubation Duration | 2-4 weeks, depending on species and substrate. |
| Contamination Prevention | Sterile techniques, HEPA filters, and alcohol wipes. |
| Colonization Signs | White mycelium fully covering the substrate. |
| Fruiting Conditions | High humidity (85-95%), cooler temps (55-65°F), and indirect light. |
| Harvest Time | When mushroom caps flatten or gills drop spores. |
| Common Mushroom Species | Oyster, Lion's Mane, Shiitake, and Reishi. |
| Storage of Spawn | Refrigerated at 35-40°F (2-4°C) for up to 6 months. |
| Success Rate | 70-90% with proper sterilization and technique. |
| Cost of Materials | $50-$200 (depending on scale and equipment). |
| Time Commitment | 4-8 weeks from inoculation to harvest. |
Explore related products
What You'll Learn
- Sterilize equipment and substrate to prevent contamination during the spore inoculation process
- Prepare spore syringes by mixing spores with sterile water for easy application
- Inoculate substrate with spores using a syringe or spore print method
- Incubate spawn jars in a dark, warm environment to encourage mycelium growth
- Transfer to bulk substrate once mycelium is fully colonized for fruiting

Sterilize equipment and substrate to prevent contamination during the spore inoculation process
Sterilization is a critical step in the process of growing mushroom spawn from spores, as it ensures that no competing microorganisms can contaminate your substrate and hinder the growth of your mushrooms. The first step in sterilization is to gather all the necessary equipment, including jars, lids, syringes, and any other tools you’ll be using. Wash everything thoroughly with hot, soapy water to remove any visible dirt or debris. After washing, rinse the equipment with clean water to remove any soap residue, as soap can inhibit mushroom growth. Once cleaned, allow the equipment to air dry completely before proceeding to the sterilization process.
For sterilizing glass jars and metal tools, the most effective method is using a pressure cooker or autoclave. Fill the pressure cooker with water, ensuring it doesn't exceed the maximum fill line, and place the jars and lids inside. The jars should be loose-lid to allow steam penetration during sterilization. Secure the pressure cooker lid and bring it to a temperature of 15 psi (pounds per square inch) for at least 30 minutes. This high-pressure steam environment will kill any bacteria, fungi, or spores that could contaminate your substrate. After sterilization, allow the pressure cooker to cool naturally; never release the pressure manually, as this can cause contamination.
The substrate, which is the material the mushroom mycelium will grow on, must also be sterilized. Common substrates include rye grains, sawdust, or straw. To sterilize grain substrates, soak them in water for 12–24 hours to hydrate them, then drain and place them in jars. Seal the jars loosely and sterilize them alongside your equipment in the pressure cooker. For sawdust or straw, chop the material into small, uniform pieces and moisten it with water until it feels like a wrung-out sponge. Place the moistened substrate into jars or bags and sterilize using the same pressure cooker method. Proper substrate sterilization is essential, as any surviving contaminants can quickly outcompete the mushroom mycelium.
After sterilization, it’s crucial to maintain a sterile environment during the inoculation process. Work in a clean area, and consider using a still air box or laminar flow hood to minimize airborne contaminants. Before opening sterilized jars or bags, flame the lids or seals with a lighter or alcohol torch to kill any surface contaminants. Use sterilized tools, such as syringes or scalpels, to transfer the spore solution or mycelium into the substrate. Any lapse in sterility at this stage can introduce contaminants that will ruin your spawn.
Finally, store your sterilized equipment and substrate in a clean, dry environment until you’re ready to inoculate. Label everything clearly to avoid confusion, as using unsterilized materials by mistake can lead to contamination. By following these detailed sterilization steps, you significantly increase the chances of successfully growing mushroom spawn from spores without contamination. Remember, patience and attention to detail are key to achieving a sterile environment for your mushroom cultivation project.
Can Cultivating Mushrooms Purify Indoor Air Quality Naturally?
You may want to see also

Prepare spore syringes by mixing spores with sterile water for easy application
Preparing spore syringes is a crucial step in the process of growing mushroom spawn from spores, as it allows for easy and controlled application of the spores to the substrate. To begin, you'll need to gather your materials: a sterile spore print or spore vial, sterile distilled water, a 10-100 ml syringe with a removable needle, and a sterile environment, such as a still air box or laminar flow hood, to work in. It's essential to maintain sterility throughout the process to prevent contamination. Start by sterilizing your work area and equipment using a disinfectant, such as 70% isopropyl alcohol, and allow it to dry completely.
Next, carefully open your spore print or vial within the sterile environment, being mindful not to introduce any contaminants. If using a spore print, gently scrape the spores into a sterile container using a sterile scalpel or inoculation loop. For spore vials, simply open the vial and prepare to transfer the spore solution. In a separate sterile container, measure out 10-20 ml of sterile distilled water, ensuring it's free from any impurities. Slowly and gently mix the spores into the water, taking care not to create air bubbles or disturb the spores excessively. The goal is to create a homogeneous suspension of spores in the water.
Once the spores are mixed with the sterile water, carefully draw the solution into the syringe using the removable needle. Remove any air bubbles by gently tapping the syringe and pushing the plunger to expel the air. Then, remove the needle and replace it with a sterile, blunt-tipped needle or simply keep the syringe without a needle for later use. Label the syringe with the date, spore species, and any relevant information to keep track of your work. Store the spore syringe in a cool, dark place, such as a refrigerator, until you're ready to use it.
When preparing multiple spore syringes, it's essential to work efficiently and maintain sterility throughout the process. Consider preparing a larger volume of spore solution and then dividing it into individual syringes to minimize the risk of contamination. Additionally, always use proper aseptic techniques, such as flaming the necks of containers and syringes with a lighter or alcohol lamp, to further reduce the risk of contamination. By following these steps, you'll have a supply of sterile spore syringes ready for application to your substrate, bringing you one step closer to successfully growing mushroom spawn from spores.
It's worth noting that the quality of your spore syringes will directly impact the success of your mushroom cultivation efforts. Always source high-quality spore prints or vials from reputable suppliers, and ensure that your equipment and environment are thoroughly sterilized before beginning the process. With patience, attention to detail, and a commitment to maintaining sterility, you'll be well on your way to preparing effective spore syringes for your mushroom cultivation projects. Remember to practice good laboratory techniques and keep detailed records of your work to refine your process and improve your results over time.
Exploring Tennessee's Forests: Can Magic Mushrooms Grow in the Volunteer State?
You may want to see also

Inoculate substrate with spores using a syringe or spore print method
Inoculating a substrate with mushroom spores is a critical step in the process of growing mushroom spawn from spores. This method involves introducing the spores into a nutrient-rich substrate, which will serve as the foundation for mycelium growth. There are two primary techniques for inoculation: using a spore syringe or applying a spore print. Both methods require a sterile environment to minimize contamination and ensure successful colonization. Before beginning, ensure your workspace is clean, and you have all necessary materials, including a sterilized substrate, spore syringe or spore print, and proper protective gear like gloves and a face mask.
When using a spore syringe, start by preparing your substrate. Common substrates include rye grains, sawdust, or a mixture of vermiculite and brown rice flour. Sterilize the substrate in a pressure cooker or autoclave to eliminate any competing microorganisms. Allow it to cool to room temperature in a clean environment. Once cooled, transfer the substrate to a sterile container or grow bag. Carefully inject the spore solution from the syringe into the substrate at multiple points to ensure even distribution. Aim for 1-2 cc of spore solution per injection, depending on the substrate volume. Seal the container or bag with a filter patch to allow gas exchange while preventing contaminants from entering.
The spore print method is another effective way to inoculate substrate. To create a spore print, place the cap of a mature mushroom gills-down on a piece of foil or glass for several hours, allowing spores to drop onto the surface. Once a sufficient spore deposit is visible, carefully transfer the spores to the sterilized substrate. Gently sprinkle the spore print over the substrate, ensuring even coverage. Alternatively, scrape the spores into a small amount of sterile water to create a makeshift spore solution, which can then be poured over the substrate. Mix the substrate thoroughly to distribute the spores evenly before transferring it to a grow bag or container with a filter patch.
Regardless of the method chosen, maintaining sterility is paramount. Work in a clean, controlled environment, such as a still air box or laminar flow hood, to minimize the risk of contamination. After inoculation, incubate the substrate in a dark, warm environment (typically 70-75°F or 21-24°C) for 2-4 weeks, depending on the mushroom species. During this time, the spores will germinate and develop into mycelium, colonizing the substrate. Regularly inspect the substrate for signs of contamination, such as mold or unusual colors, and discard any compromised batches.
Both the syringe and spore print methods have their advantages. The spore syringe offers precision and consistency, making it ideal for beginners or large-scale cultivation. The spore print method, while slightly more hands-on, is cost-effective and accessible, as it requires minimal equipment. Whichever method you choose, patience and attention to detail are key to successfully inoculating your substrate and growing healthy mushroom spawn. With proper care, you’ll soon have a thriving mycelium network ready for fruiting.
Exploring Porcini Mushrooms: Natural Habitats and Ideal Growing Conditions
You may want to see also
Explore related products

Incubate spawn jars in a dark, warm environment to encourage mycelium growth
Once you’ve prepared your spawn jars with a sterilized substrate and introduced mushroom spores, the next critical step is incubation. Incubating spawn jars in a dark, warm environment is essential to encourage mycelium growth, as these conditions mimic the natural habitat where mushrooms thrive. Mycelium, the vegetative part of the fungus, requires consistent warmth and darkness to colonize the substrate effectively. The ideal temperature range for most mushroom species is between 70°F and 75°F (21°C to 24°C). Ensure your incubation area is stable within this range, as fluctuations can slow down or halt mycelium growth. Use a thermometer to monitor the temperature and adjust as needed.
Darkness is equally important during this phase, as light can inhibit mycelium development and encourage premature fruiting. Store your spawn jars in a closed cabinet, closet, or a dedicated incubation chamber where light exposure is minimal or nonexistent. If your incubation area has windows or light sources, cover the jars with a light-blocking material like a dark cloth or aluminum foil to ensure complete darkness. Avoid opening the jars or disturbing them unnecessarily, as introducing contaminants or light can disrupt the growth process.
The incubation period typically lasts 2 to 4 weeks, depending on the mushroom species and environmental conditions. During this time, the mycelium will gradually spread throughout the substrate, turning it white and fuzzy as it colonizes. Patience is key, as rushing the process can lead to incomplete colonization or contamination. Regularly inspect the jars for any signs of mold or unusual colors, which may indicate contamination. If contamination is detected, isolate the affected jar immediately to prevent it from spreading to others.
Maintaining proper humidity around the jars is also beneficial, though not as critical as temperature and darkness. A slightly humid environment can help prevent the substrate from drying out, but avoid excessive moisture, as it can promote bacterial or mold growth. If needed, place a tray of water near the jars to maintain ambient humidity without directly exposing them to water.
Once the substrate is fully colonized by the mycelium, the spawn jars are ready for the next stage of the mushroom cultivation process. At this point, the mycelium has established a strong network and is prepared to fruit under the right conditions. Proper incubation in a dark, warm environment is the foundation for healthy mycelium growth, setting the stage for a successful mushroom harvest.
Psilocybe Mushrooms in Colorado: Where and How They Grow
You may want to see also

Transfer to bulk substrate once mycelium is fully colonized for fruiting
Once your mycelium has fully colonized the spawn substrate, it’s time to transfer it to a bulk substrate to initiate fruiting. This step is crucial for providing the mycelium with the nutrients and environment it needs to produce mushrooms. Begin by preparing your bulk substrate, which typically consists of a mixture of materials like straw, wood chips, coconut coir, or manure, depending on the mushroom species. Sterilize or pasteurize the substrate to eliminate competing organisms, ensuring a clean environment for your mycelium to thrive. For pasteurization, soak the substrate in hot water (160-180°F or 71-82°C) for about an hour, then drain and cool it to room temperature. Sterilization, often done in a pressure cooker, is more thorough but may not be necessary for all substrates or mushroom types.
After your bulk substrate is ready, transfer the fully colonized spawn to it in a sterile environment, such as a still air box or glove box, to minimize contamination. Break up the spawn into smaller pieces to increase the surface area for mycelial growth. Mix the spawn thoroughly but gently into the bulk substrate, ensuring even distribution. Aim for a spawn-to-substrate ratio of about 1:10 to 1:5, depending on the mushroom species and substrate density. Place the inoculated bulk substrate into a container with small holes for gas exchange, such as a monotub or grow bag, to maintain humidity while allowing carbon dioxide to escape.
Maintain optimal conditions for mycelial colonization of the bulk substrate, typically at temperatures between 70-75°F (21-24°C) and high humidity levels. Keep the substrate slightly moist but not waterlogged, as excess moisture can lead to contamination. Over the next 2-4 weeks, the mycelium will colonize the bulk substrate, turning it completely white. Monitor the process and ensure the environment remains clean and stable. Avoid disturbing the substrate during this phase to prevent contamination and allow the mycelium to establish itself fully.
Once the bulk substrate is fully colonized, it’s time to induce fruiting. This involves exposing the mycelium to conditions that mimic the mushroom’s natural fruiting environment. Introduce fresh air by increasing ventilation, and lower the temperature slightly to the species-specific fruiting range, often around 55-70°F (13-21°C). Maintain high humidity by misting the substrate or using a humidifier, and ensure adequate light, typically indirect natural light or a few hours of artificial light daily. Some species may require a period of darkness followed by light to initiate pinning, so research your specific mushroom’s needs.
Within a week or two, you should see tiny mushroom pins forming on the surface of the substrate. These pins will grow into mature mushrooms over the following days. Continue to maintain proper humidity, ventilation, and light levels during this fruiting phase. Harvest the mushrooms when the caps are fully open but before the spores drop to encourage multiple flushes. After the first harvest, rehydrate the substrate if necessary and maintain fruiting conditions to potentially yield additional flushes of mushrooms. Proper care during the transfer and fruiting stages will maximize your yield and ensure a successful mushroom cultivation cycle.
Cultivating Hemlock Reishi Mushrooms: A Step-by-Step Growing Guide
You may want to see also
Frequently asked questions
The first step is to sterilize your substrate (such as grain or sawdust) and prepare a sterile environment to prevent contamination.
Collect spores by placing a mature mushroom cap gill-side down on a piece of foil or glass overnight. The spores will drop and form a print, which can be used to inoculate sterile agar or liquid culture.
Common substrates include rye grain, wheat berries, or sawdust, depending on the mushroom species. Rye grain is often preferred for its high nutrient content and ease of sterilization.
Colonization time varies by species and conditions but typically takes 2–4 weeks. Maintain a warm, dark, and sterile environment to encourage growth.
While possible, it’s less reliable than using a fully colonized spawn. Spore syringes are best used to create a liquid culture or inoculate agar, which is then transferred to grain spawn for better results.